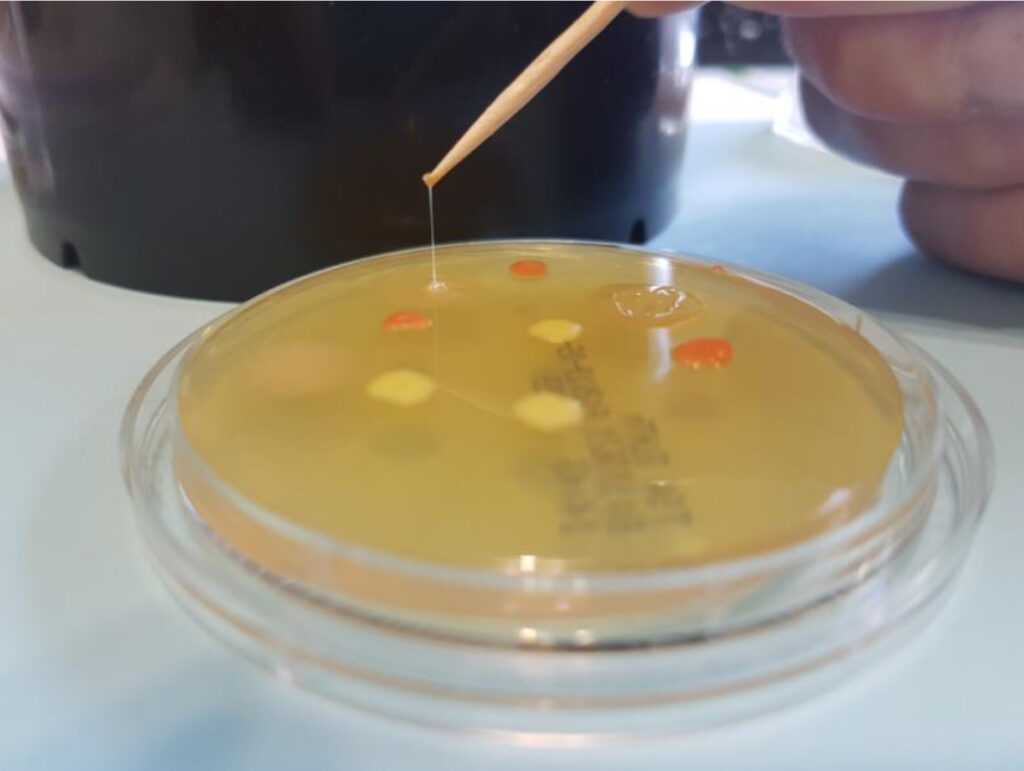

GRAM INMEDIATO NEOGRAM FILAMENTA TODA COLONIA GRAM NEGATIVA Y NO FILAMENTA TODA COLONIA GRAM POSITIVA, EN SEGUNDOS
M-IDENT NEOGRAM es un test rápido para la diferenciación inmediata de Gram en colonias bacterianas in vitro.
M-IDENT NEOGRAM altera la pared de las bacterias Gram Negativas, transformando instantáneamente la colonia bacteriana en un filamento muy parecido a la fibrina, bien visible a simple vista.
Cuando el aspecto de la colonia no permite estar seguro del grupo bacteriano al que pertenece, es necesario realizar la clásica y larga tinción de Gram.
NEOGRAM permite conocer en 20 escasos segundos la diferenciación de Gram de las colonias aisladas en los medios de cultivo. La correlación con la tinción de Gram es total.
El ahorro de tiempo es notorio en la fase previa a la elección de las galerías o pruebas a utilizar en la identificación.
Si es necesario concretar la morfología celular, NEOGRAM puede complementarse con un examen microscópico.
La formación de un filamento elástico que une la gota de NEOGRAM o el palillo con la colonia es indicadora de bacteria Gram Negativa.
La no formación de dicho filamento es indicadora de bacteria Gram Positiva. En este caso, es recomendable repetir la prueba para confirmar.
El reactivo destruye la colonia, por lo que si se requieren pruebas posteriores, hay que haberla repicado antes.
Precaución: corrosivo, no tocar ni inhalar. Contiene bases fuertes.
GRAM INMEDIATO NEOGRAM FILAMENTA TODA COLONIA GRAM NEGATIVA Y NO FILAMENTA TODA COLONIA GRAM POSITIVA, EN SEGUNDOS
https://www.microkit.es/fichas/NEOGRAM-M-IDENT-REACTIVO-GRAM-KIT.pdf
Tambien en video:
Para más información sobre nuestros kit M-IDENT NEOGRAM, no dude en ponerse en contacto con nosotros a través de nuestro correo electrónico microkit@microkit.es o por teléfono en el nº 91-897 46 16.


